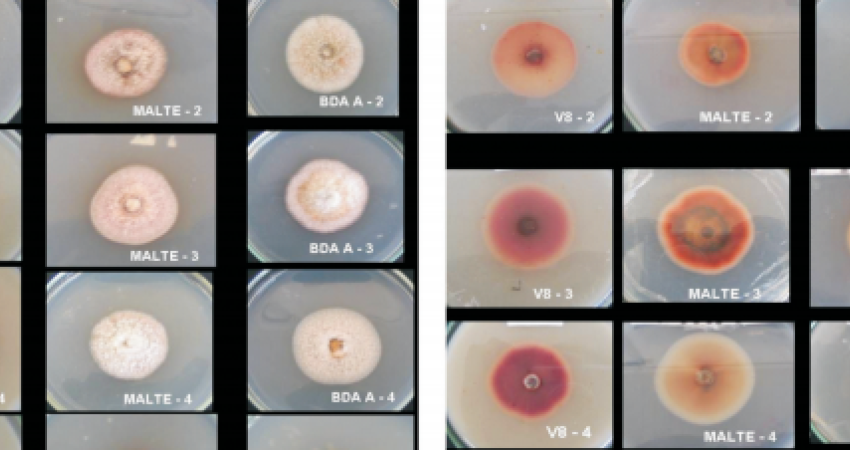

BLOG
Caracterização morfológica de isolados de Cryptosporiopsis perennans em diferentes meios de cultura
21/02/2017
VER ANEXO
I Congresso de Inovação e Tecnologia da Maçã
O I CITEM acontecerá entre os dias 08 a 10 de maio de 2024. acesse o link para maiores ...
Seminário sobre queima das maçãs pelo sol e estresse ...
Tópicos da apresentação: - Conceito de Qualidade; - Sintomas de Queimadura de sol (QS); - Classificação de ...
QUER FICAR SEMPRE
POR DENTRO DAS
ÚLTIMAS NOVIDADES?